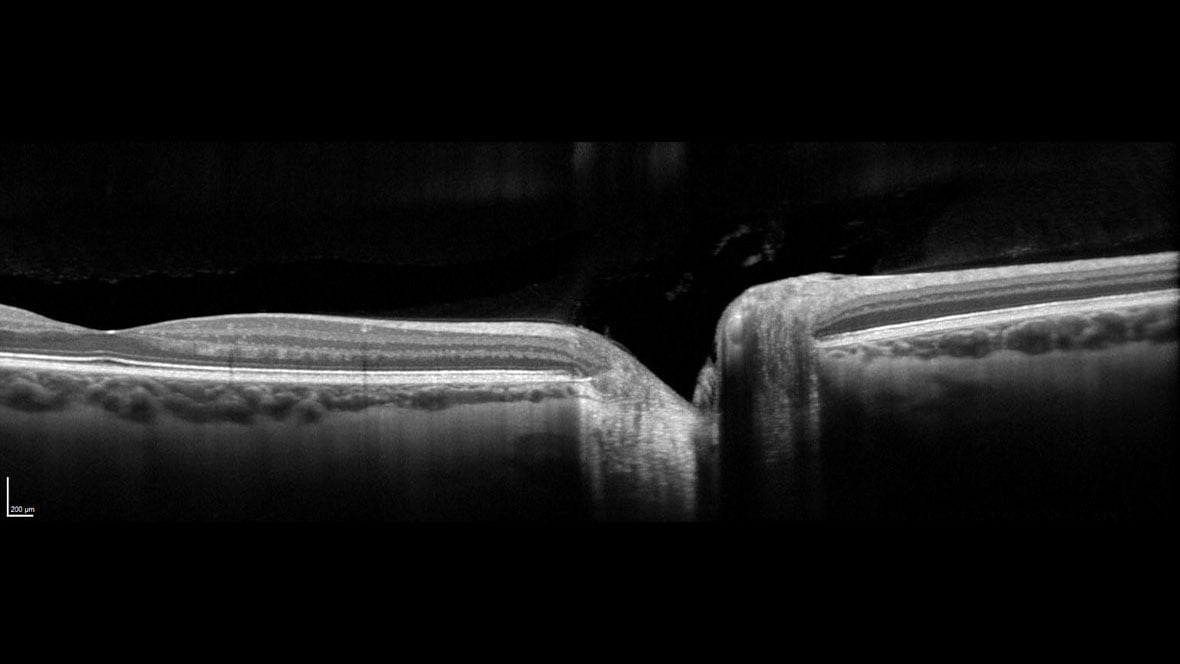

Choose the speed you need with SHIFT technology
The SPECTRALIS SHIFT technology enables adaptation to the unique needs of the patient and clinic workflow by offering changeable OCT scan speeds. Use 20 kHz for maximum detail in eyes that are challenging to image, 85 kHz for optimal balance of speed and image quality, and 125 kHz for rapid scanning in time-sensitive or high-volume settings.